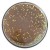

Popis 50g - Obalovacie cesto Berkley PowerBait Original Trout Bait
S nástrahami Berkley PowerBait sú začínajúci rybári dobrí a dobrí rybári skvelí! Vedci spoločnosti Berkley strávili viac ako 25 rokov zdokonaľovaním neodolateľnej vône a chuti – exkluzívnej formuly PowerBait. Ryby si nástrahu PowerBait obľúbili natoľko, že sa na nej držia 18-krát dlhšie, čo vám dáva čas a istotu, že ucítite viac záberov – nastražíte viac háčikov a ulovíte viac rýb!
- Ľahko tvarovateľný a použiteľný
- Plávajúce zloženie zvyšuje rozptyl vône a chuti
Typ produktu: Obaľovacie cesto
Obsah balenia: 50 g
Balenie: dóza (jar)
Určené pre: Pstruhy v sladkej vode
50g - Obalovacie cesto Berkley PowerBait Original Trout Bait
-
Príchuť PowerBait®Balenie 50gr
6,99 €-5%História cien1. Tropická cena výrobku: 6,64 € -5%2. Predajná cena výrobku: 6,99 €6,64 €Cena so zľavovým kódomZACINAME -4%6,37 € -
6,99 €-5%História cien1. Tropická cena výrobku: 6,64 € -5%2. Predajná cena výrobku: 6,99 €6,64 €Cena so zľavovým kódomZACINAME -4%6,37 € -
6,99 €-5%História cien1. Tropická cena výrobku: 6,64 € -5%2. Predajná cena výrobku: 6,99 €6,64 €Cena so zľavovým kódomZACINAME -3%6,44 € -
6,99 €-5%História cien1. Tropická cena výrobku: 6,64 € -5%2. Predajná cena výrobku: 6,99 €6,64 €Cena so zľavovým kódomZACINAME -4%6,37 € -
Príchuť PowerBait®Balenie 50gr
6,99 €-5%História cien1. Tropická cena výrobku: 6,64 € -5%2. Predajná cena výrobku: 6,99 €6,64 €Cena so zľavovým kódomZACINAME -4%6,37 € -
6,99 €-5%História cien1. Tropická cena výrobku: 6,64 € -5%2. Predajná cena výrobku: 6,99 €6,64 €Cena so zľavovým kódomZACINAME -4%6,37 € -
Príchuť Royal RaveBalenie 50gr
6,99 €-5%História cien1. Tropická cena výrobku: 6,64 € -5%2. Predajná cena výrobku: 6,99 €6,64 €Cena so zľavovým kódomZACINAME -4%6,37 € -
6,99 €-5%História cien1. Tropická cena výrobku: 6,64 € -5%2. Predajná cena výrobku: 6,99 €6,64 €Ďalšie zľavy až 12 % pre registrovaných používateľov! Strážiť dostupnosť a cenu Pridať do obľúbenýchCena so zľavovým kódomZACINAME -4%6,37 € -
6,99 €-5%História cien1. Tropická cena výrobku: 6,64 € -5%2. Predajná cena výrobku: 6,99 €6,64 €Ďalšie zľavy až 12 % pre registrovaných používateľov! Strážiť dostupnosť a cenu Pridať do obľúbenýchCena so zľavovým kódomZACINAME -4%6,37 € -
6,99 €-5%História cien1. Tropická cena výrobku: 6,64 € -5%2. Predajná cena výrobku: 6,99 €6,64 €Ďalšie zľavy až 12 % pre registrovaných používateľov! Strážiť dostupnosť a cenu Pridať do obľúbenýchCena so zľavovým kódomZACINAME -4%6,37 € -
Príchuť Marshmallow WhiteBalenie 50g
6,99 €-5%História cien1. Tropická cena výrobku: 6,64 € -5%2. Predajná cena výrobku: 6,99 €6,64 €Ďalšie zľavy až 12 % pre registrovaných používateľov! Strážiť dostupnosť a cenu Pridať do obľúbenýchCena so zľavovým kódomZACINAME -4%6,37 € -
6,99 €-5%História cien1. Tropická cena výrobku: 6,64 € -5%2. Predajná cena výrobku: 6,99 €6,64 €Ďalšie zľavy až 12 % pre registrovaných používateľov! Strážiť dostupnosť a cenu Pridať do obľúbenýchCena so zľavovým kódomZACINAME -4%6,37 € -
Príchuť PowerBaitBalenie 50grFarba Crazy Carnival
6,99 €-5%História cien1. Tropická cena výrobku: 6,64 € -5%2. Predajná cena výrobku: 6,99 €6,64 €Ďalšie zľavy až 12 % pre registrovaných používateľov! Strážiť dostupnosť a cenu Pridať do obľúbenýchCena so zľavovým kódomZACINAME -4%6,37 € -
6,99 €-5%História cien1. Tropická cena výrobku: 6,64 € -5%2. Predajná cena výrobku: 6,99 €6,64 €Ďalšie zľavy až 12 % pre registrovaných používateľov! Strážiť dostupnosť a cenu Pridať do obľúbenýchCena so zľavovým kódomZACINAME -4%6,37 € -
6,99 €-5%História cien1. Tropická cena výrobku: 6,64 € -5%2. Predajná cena výrobku: 6,99 €6,64 €Ďalšie zľavy až 12 % pre registrovaných používateľov! Strážiť dostupnosť a cenu Pridať do obľúbenýchCena so zľavovým kódomZACINAME -4%6,37 € -
6,99 €-5%História cien1. Tropická cena výrobku: 6,64 € -5%2. Predajná cena výrobku: 6,99 €6,64 €Ďalšie zľavy až 12 % pre registrovaných používateľov! Strážiť dostupnosť a cenu Pridať do obľúbenýchCena so zľavovým kódomZACINAME -4%6,37 € -
6,99 €-5%História cien1. Tropická cena výrobku: 6,64 € -5%2. Predajná cena výrobku: 6,99 €6,64 €Ďalšie zľavy až 12 % pre registrovaných používateľov! Strážiť dostupnosť a cenu Pridať do obľúbenýchCena so zľavovým kódomZACINAME -4%6,37 €
- Výrobca Berkley
- Záruka 24 mesiacov
Popis 50g - Obalovacie cesto Berkley PowerBait Original Trout Bait
S nástrahami Berkley PowerBait sú začínajúci rybári dobrí a dobrí rybári skvelí! Vedci spoločnosti Berkley strávili viac ako 25 rokov zdokonaľovaním neodolateľnej vône a chuti – exkluzívnej formuly PowerBait. Ryby si nástrahu PowerBait obľúbili natoľko, že sa na nej držia 18-krát dlhšie, čo vám dáva čas a istotu, že ucítite viac záberov – nastražíte viac háčikov a ulovíte viac rýb!
- Ľahko tvarovateľný a použiteľný
- Plávajúce zloženie zvyšuje rozptyl vône a chuti
Typ produktu: Obaľovacie cesto
Obsah balenia: 50 g
Balenie: dóza (jar)
Určené pre: Pstruhy v sladkej vode
6 dôvodov, prečo
nakúpiť u nás
Spoznajte nás
-
Doprava pri nákupe od 70 € zadarmo
-
Založené v roku 2000 - tradícia predaja už 26 rokov
-
Benefity pre stálych aj nových zákazníkov
-
Možnosť vrátenia tovaru do 14 dní
-
Najširší sortiment - v ponuke viac ako 100 000 produktov
-
Rybolovu rozumieme - v teame je aj majster sveta